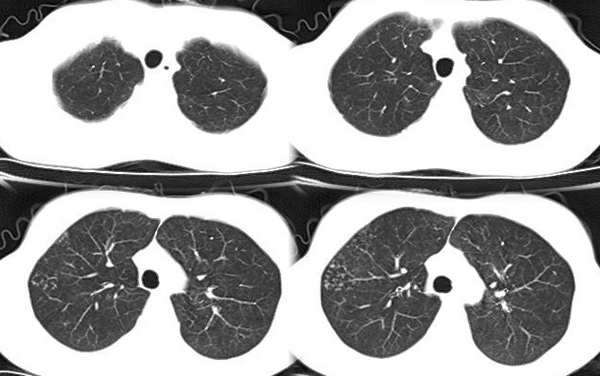
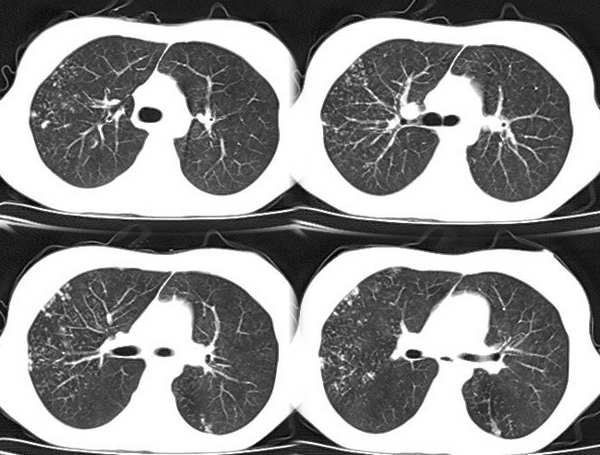

以下是引用x线在2006-2-2 17:37:00的发言:[br]结合病史支持“ct拟诊:双侧tb,左下叶结核球,左下叶局限性轻度支扩。”双下叶及左舌叶淡薄的毛玻璃密度影,我考虑为炎性渗出。另:是否合并霉菌感染须进一步检查确定。

以下是引用x线在2006-2-2 17:37:00的发言:[br]结合病史支持“ct拟诊:双侧tb,左下叶结核球,左下叶局限性轻度支扩。”双下叶及左舌叶淡薄的毛玻璃密度影,我考虑为炎性渗出。另:是否合并霉菌感染须进一步检查确定。
| 欢迎光临 医影在线 (http://bbs.radida.com/bbs/) | Powered by Discuz! X3.2 |